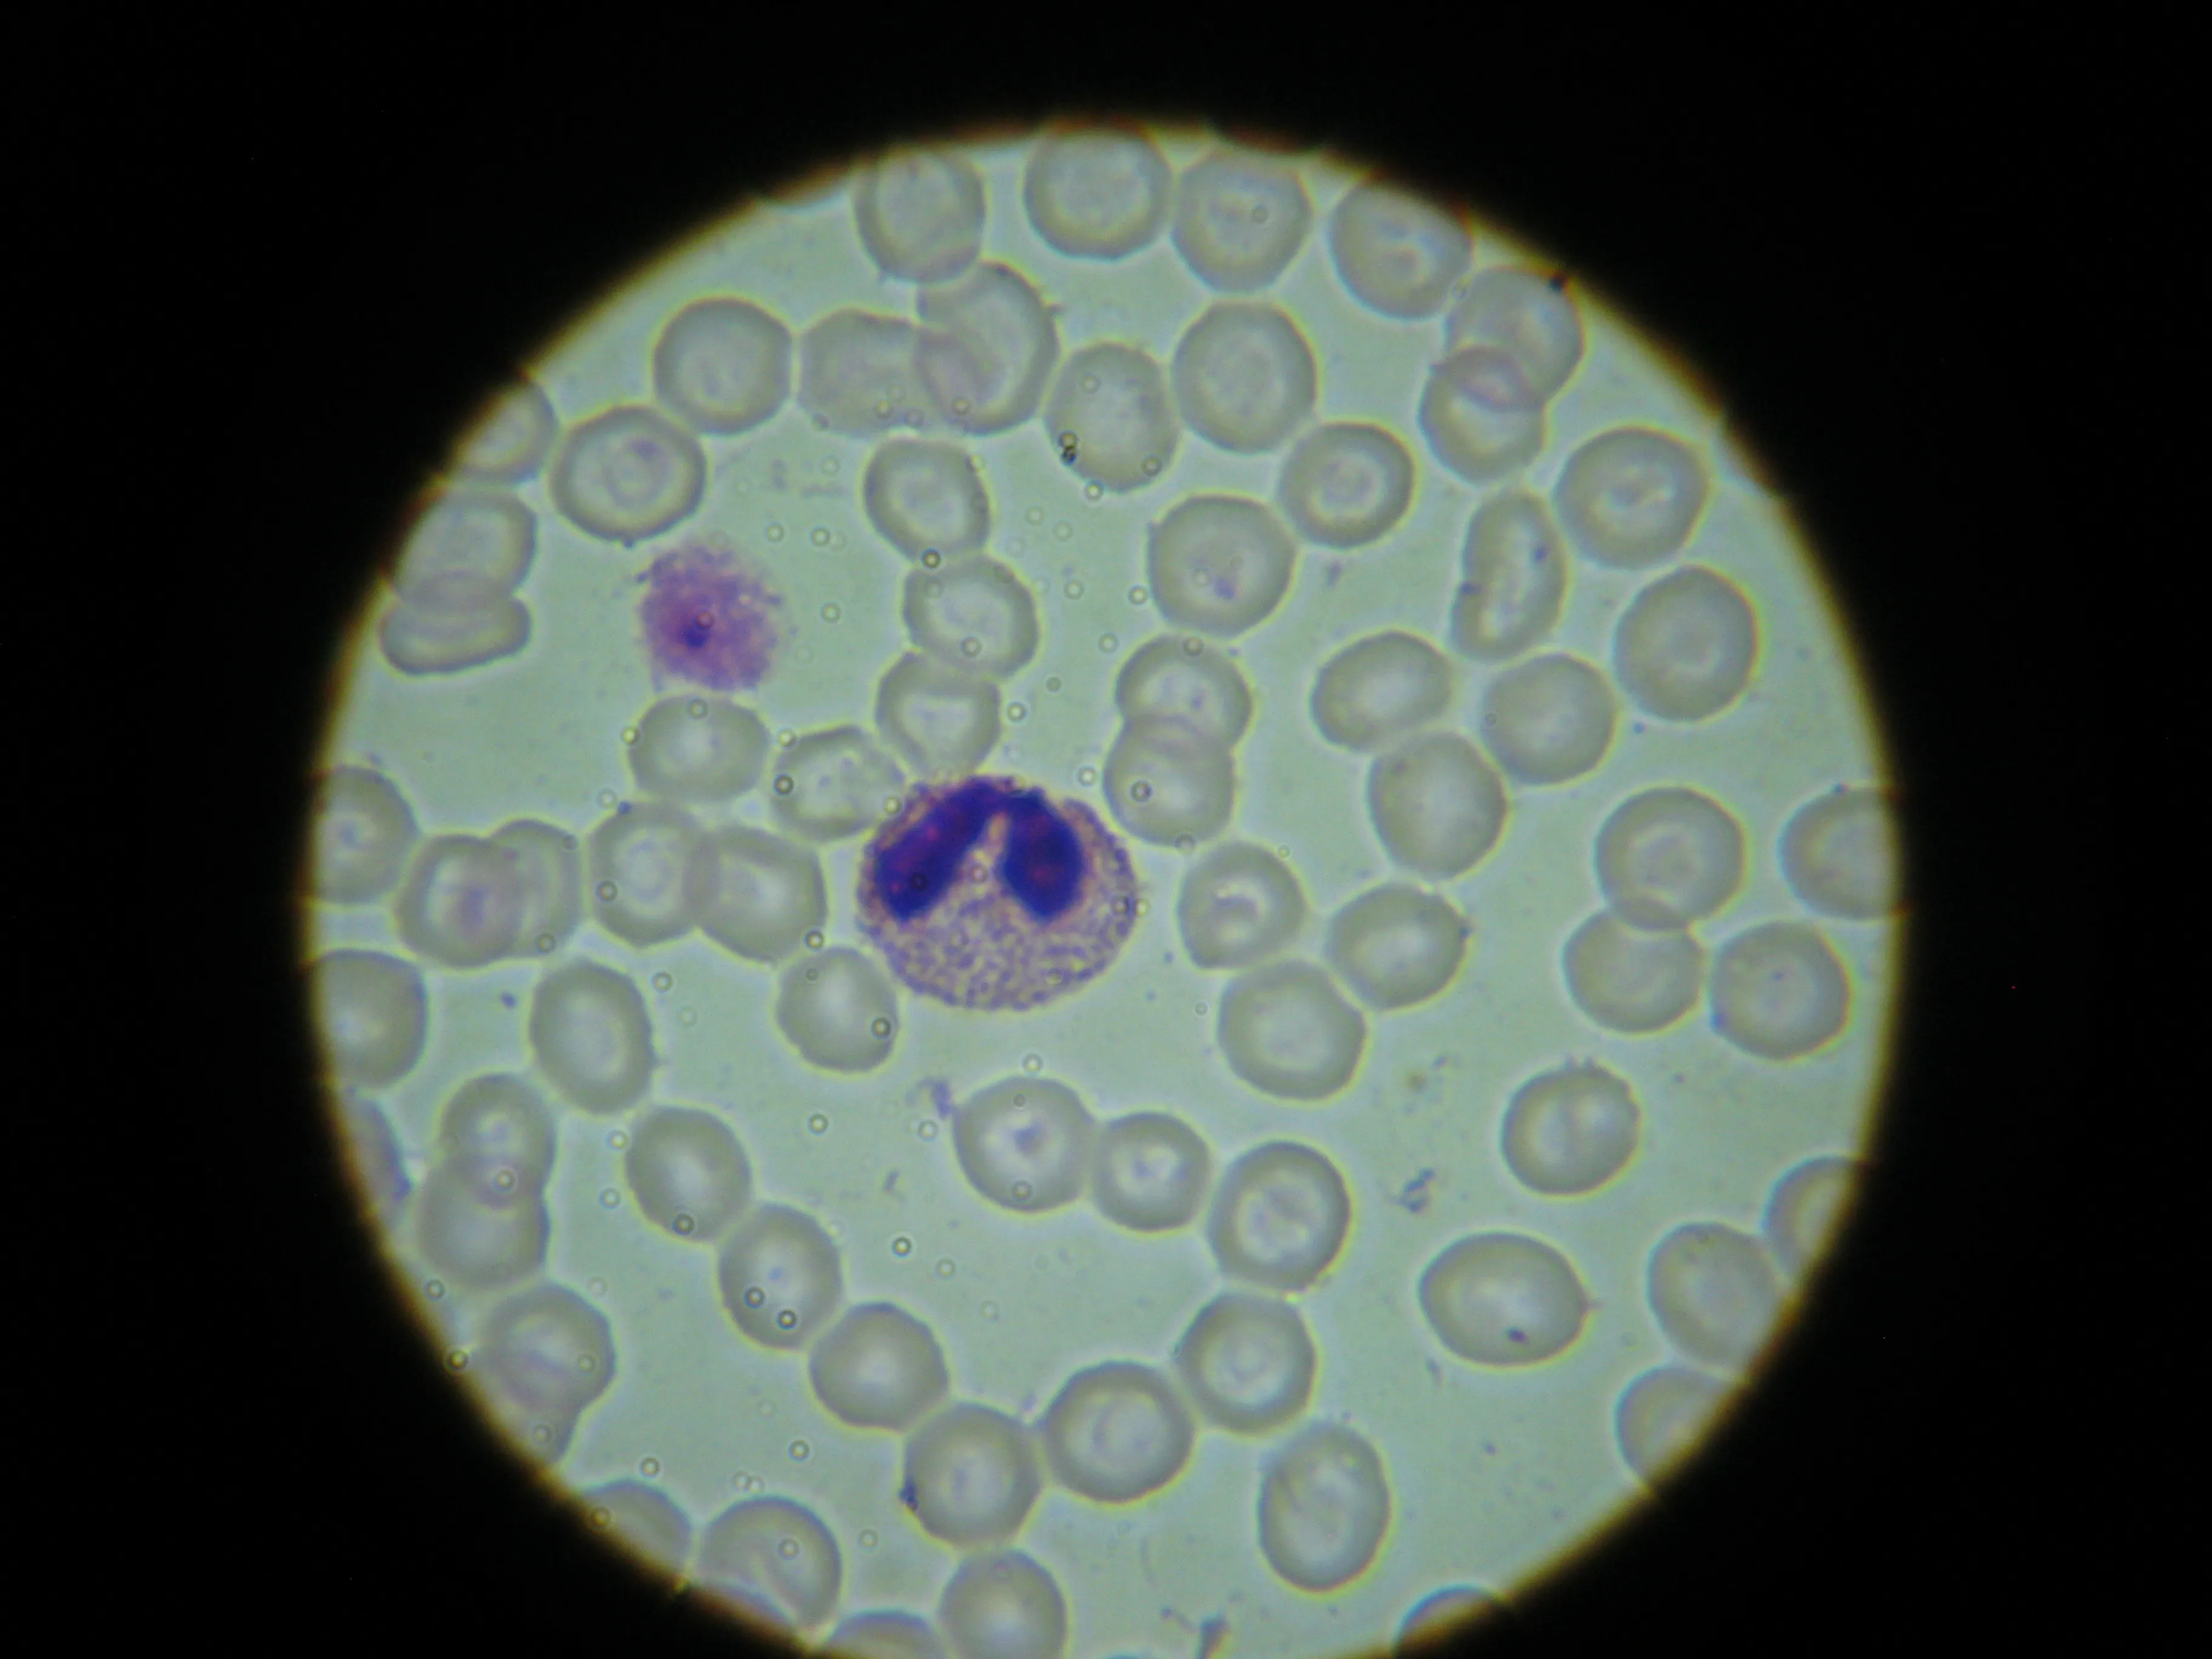

Microscope achromatique 4x10x20x40x60x100x Plan, lentille d'objectif, accessoires de haute qualité
17.59
–
282.66
$
14
commandes
/
1
avis
Évolution du prix
- pour 3 mois
- pour un semestre
- Nécessite l'extension Alitools
L'extension Alitools est nécessaire pour suivre un article et recevoir des notifications lorsque les prix baissent.
Avis de baisse de prix
16.71 $ (-5%)
16.71 $ (-5%)
15.83 $ (-10%)
14.95 $ (-15%)
14.07 $ (-20%)
Notre bot Telegram vous informera dès que le prix aura baissé jusqu'au prix souhaité